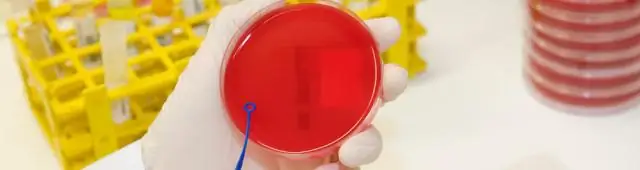
Новое понимание бактериальных токсинов

Токсин, вырабатываемый бактерией, вызывающей инфекции мочевыводящих путей, связан с токсином, вызывающим коклюш, но отличается от него, согласно новому исследованию. Выводы, которые будут опубликованы в выпуске журнала «The Journal of Biological Chemistry» от 8 сентября, могут помочь в разработке новых вакцин.
Ключевым ингредиентом существующей вакцины против коклюша является неактивная форма коклюшного токсина. Активный коклюшный токсин проникает в лейкоциты и химически модифицирует категорию G-белков, которые являются важными сигнальными молекулами. Эти модифицированные G-белки больше не способны связываться со своими рецепторами, что нарушает важную передачу сигналов внутри клетки, локально отключая иммунный ответ и позволяя бактериям размножаться. Неактивный коклюшный токсин, обнаруженный в вакцине, учит иммунную систему избегать такого молчания.
Белки, подобные коклюшному токсину, вырабатываются многими бактериями, но относительно мало известно о том, что они делают и как они работают. Исследовательская группа под руководством Джейми Россджона из Университета Монаш в Мельбурне, Австралия, была заинтересована в изучении разнообразия малоизученных токсинов, подобных коклюшу, и в изучении того, что можно извлечь из них.
«[Коклюшный токсин] - действительно удивительная молекула, и она очень важна для вакцины против коклюша», - сказала Дене Литтлер, научный сотрудник, руководившая работой. «Я был очень взволнован идеей, что могут быть другие формы этого токсина в других бактериях, возможно, в бактериях, которые вызывают длительные хронические инфекции, когда бактериям совершенно необходимо отключить иммунную систему, чтобы жить."
Литтлер и его коллеги искали среди опубликованных геномов бактерий последовательности ДНК, подобные тем, которые кодируют токсин коклюша. Они обнаружили ряд коклюшноподобных последовательностей токсинов в геномах подмножества штаммов кишечной палочки, которые могут благополучно жить в кишечнике, но вызывать симптомы при попадании в кровь или мочевыводящие пути. Это было ключом к тому, что коклюшноподобные токсины широко распространены среди патогенной E. coli, но было неизвестно, действует ли коклюшноподобный токсин E. coli, или EcPlt, так же, как коклюшный токсин.
«Меня особенно интересовало, что происходит, когда токсины [продуцируемые кишечной палочкой] оказываются внутри клетки», - сказал Литтлер. Многие исследования бактериальных токсинов изучают то, как токсины впервые попадают в клетки и их влияние на клетку, а не то, как именно токсин изменяется - и меняется - во внутриклеточной среде.
Команда провела биохимические исследования EcPlt из бактериального штамма, вызывающего инфекции мочевыводящих путей. Они подготовили первый отчет об активной форме EcPlt внутри клеток человека, описав, как химическая среда внутри клетки заставляет белок изменять форму и активироваться.
Они также обнаружили, что, хотя EcPlt модифицирует тот же G-белок и нарушает тот же сигнальный путь, что и коклюшный токсин, он делает это немного иначе. Токсин коклюша способен модифицировать только одну конкретную аминокислоту в G-белке человека-мишени; если эта аминокислота изменится, G-белок больше не будет подвергаться воздействию коклюшного токсина. EcPlt, с другой стороны, модифицировал другую аминокислоту, но аналогичным образом нарушал передачу сигналов G-белка.
«Возможно, то, как это делает коклюш [эта модификация], просто труднее отменить человеческим клеткам», - сказал Литтлер, размышляя о том, почему коклюш, вызванный токсином коклюша, является более тяжелым заболеванием, чем инфекции мочевыводящих путей, вызванные Бактерии, продуцирующие EcPlt.
Литтлер надеется, что понимание естественного разнообразия коклюшных токсинов может помочь улучшить существующие вакцины и создать новые.
«Структуры наших токсинов помогают определить, как функционируют коклюшно-подобные токсины, и помогают определить способы производства неактивных версий», - сказал Литтлер. «Компонент коклюшного токсина в вакцине DTaP очень эффективен. Вакцины, направленные против других коклюшноподобных белков, могут быть столь же эффективными в предотвращении заболевания».